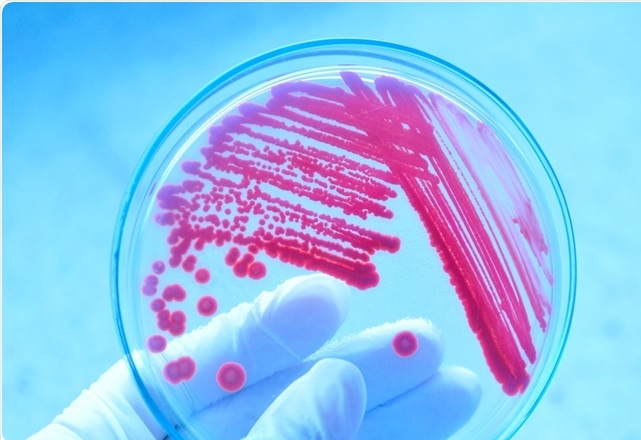

- Teacher: Asangulova Alina Kubanychbekovna
- Teacher: Sulajmanova Cholpon Tashtanbekovna
- Teacher: Ashyralieva D O
- Teacher: Marina Dujshenkulova
- Teacher: Sataeva Nargiza Usonbekovna
- Teacher: Olga Nikolaevna Gavrilova
- Teacher: Tumonbaeva Zharkynaj Sapishevna
- Teacher: Kurzhunbaeva Zhyldyz Bekbaatyrovna
- Teacher: Derbishalieva Zhypar Kakilovna